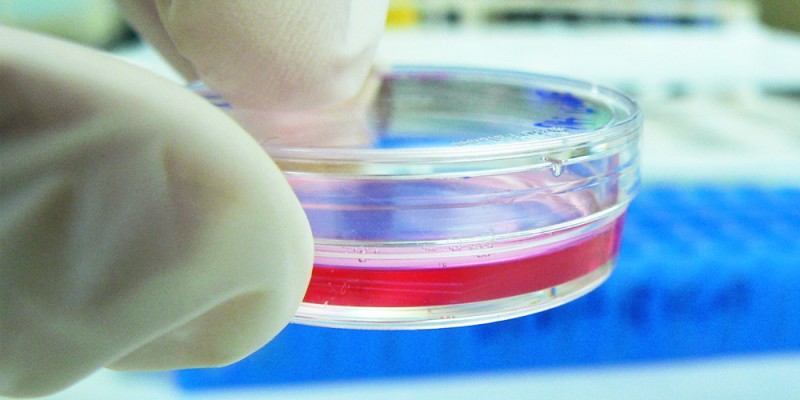
cultivo

Logran regenerar totalmente piel de ratones con células madre

STAFF/ @michangoonga
En medicina un gran desafío consiste en lograr la regeneración completa de la piel, después de haber sufrido accidentes o lesiones, por los que hubiera quedado dañada o destruida. El uso de células madre ayuda en este propósito.
Investigadores del Guangzhou Red Cross Hospital Medical College en China han estudiado el uso de células madre epidérmicas como «apósitos» regenerativos de la piel de ratones. Cultivan estas herramientas celulares con unas membranas de quitina y colágeno modificado, buscando que las células madre pudieran diferenciarse en todos los tipos celulares de la piel.
Las membranas servirían en cierta manera como plataformas celulares, para lograr que las células madre formaran tiritas de piel que pudieran ser insertadas en ratones cuyo tejido epidérmico hubiera sido dañado previamente.
Los resultados, publicados en la revista PLOS One, han confirmado que el uso de estos estructuras celulares (conocidos en inglés como scaffolds) ayuda a la diferenciación de estas células madre. A pesar de que las pruebas han sido realizadas en roedores, el éxito de estos apósitos de piel fabricada en el laboratorio ha tenido gran éxito.
Info: ALT1040